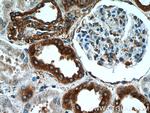
RPLP1 Antibody in Immunohistochemistry (Paraffin) (IHC (P))

Search
Proteintech
RPLP1 Polyclonal Antibody
{{$productOrderCtrl.translations['antibody.pdp.commerceCard.promotion.promotions']}}
{{$productOrderCtrl.translations['antibody.pdp.commerceCard.promotion.viewpromo']}}
{{$productOrderCtrl.translations['antibody.pdp.commerceCard.promotion.promocode']}}: {{promo.promoCode}} {{promo.promoTitle}} {{promo.promoDescription}}. {{$productOrderCtrl.translations['antibody.pdp.commerceCard.promotion.learnmore']}}
产品信息
21636-1-AP
种属反应
宿主/亚型
分类
类型
抗原
偶联物
形式
浓度
规格
纯化类型
保存液
内含物
保存条件
运输条件
产品详细信息
Immunogen sequence: MASVSELAC IYSALILHDD EVTVTEDKIN ALIKAAGVNV EPFWPGLFAK ALANVNIGSL ICNVGAGGPA PAAGAAPAGG PAPSTAAAPA EEKKVEAKKE ESEESDDDMG FGLFD (1-114 aa encoded by BC003369)
靶标信息
Ribosomes, the organelles that catalyze protein synthesis, are composed of a small subunit (40S) and a large subunit (60S) that consist of over 80 distinct ribosomal proteins. Mammalian ribosomal proteins are encoded by multigene families that contain processed pseudogenes and one functional intron-containing gene within their coding regions. Ribosomal Protein LP1 (ribosomal protein, large, P1), also known as 60S acidic ribosomal protein P1, RPP1 or RPLP1, is a 114 amino acid acidic protein that belongs to the ribosomal protein L12P family. A key component during the elongation step of protein synthesis, Ribosomal Protein LP1 forms a pentameric complex (in conjunction with LP2 and LP0) that regulates ribosome assembly and plays a role in translation initiation. Like other mammalian ribosomal proteins, Ribosomal Protein LP1 exists as multiple processed pseudogenes that are found throughout the genome.
仅用于科研。不用于诊断过程。未经明确授权不得转售。
生物信息学
蛋白别名: 60S acidic ribosomal protein P1; acidic ribosomal phosphoprotein (P1); acidic ribosomal phosphoprotein P1; L RPP1; Large ribosomal subunit protein P1; ribosomal protein, large, P1; RPLP1
基因别名: 2410042H16Rik; Arpp1; C430017H15Rik; LP1; P1; RPLP1; RPP1; RRP1
UniProt ID: (Human) P05386, (Mouse) P47955
Entrez Gene ID: (Human) 6176, (Mouse) 56040